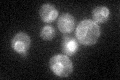
YEL017W
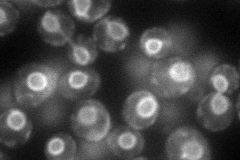
YEL017W
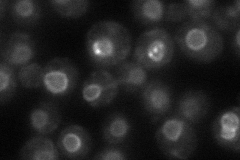
YEL017W
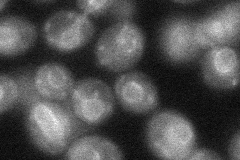
YEL017W
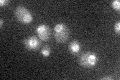
YEL017W

View description
Protein of unknown function with a possible role in glutathione metabolism, as suggested by computational analysis of large-scale protein-protein interaction data; GFP-fusion protein localizes to the nuclear periphery
Localization:
Intensity:
Fold change:
Significance:
-
C’ GFP library in SD
nuclear periphery29.66 -
N' NOP1pr-GFP in SD
nuclear periphery79.9176 -
N' TEF2pr-mCherry in SD

ER134.32 -
N' NATIVEpr-GFP in SD
nuclear periphery52.4944 -
N' TEF2pr-VC and Cyto-VN in SD
nuclear periphery37.0391 -
C’ GFP library in SD+DTT

nuclear periphery25.840.87No -
C’ GFP library in SD+H2O2

nuclear periphery25.770.86No -
C’ GFP library in Starvation Media
nuclear periphery22.820.76No -
C’ GFP library on the background of Pup2-DaMP

nuclear periphery -
C’ GFP library on the background of CCT mutant

nuclear periphery29.19410.98403No
